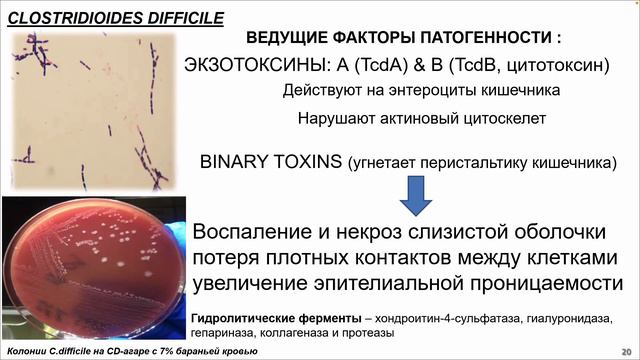
Сухина М.А.«Вопросы лабораторной диагностики Clostridium difficile-ассоциированной диареи (CDI)» смотреть онлайн

Автор: Горячий сон Страница 4

PAT MCGRATH Celestial Divinity: MTHRSHP Mega Review + 2 Eyeshadow Look Tutorial |WATCH Before Buyin

Space Acacia: The Ultimate 3-In-1 Camping System

REPLANTE DA PHALAENOPSIS AZUL ... OU BRANCA? KKK✴️
Сухина М.А.«Вопросы лабораторной диагностики Clostridium difficile-ассоциированной диареи (CDI)»

#HOLYGRAILORCHID AN ORCHID A DAY: EPISODE 111 NEW BUCKLIST ORCHID

Modern Coworth Park wedding flowers -- Purity

WHETHER YOU EAT OR DRINK, DO IT ALL TO THE GLORY OF GOD! 1 Cor. 10:31

Вечерняя прогулка с Аделькой. Миллион роз на улицах нашего поселка. Гуляем и любуемся красотой!

Как ухаживать за бегонией в домашних условиях?

Хургада 2019

Guitar Cover: "22 Acacia Avenue" - IRON MAIDEN (learned by ear)

Sansevieria SILVER BLUE var kuning..Perawatan ala petani sansevieria milineal

Palma Airport - PMI - exit from coach park onto Motorway

Maenam Village - Samui Island

Hotel Stay at Atlantis The Palm, Dubai | Travel Center UK

Роскошный рододендрон

#Hike to Barsey Hill #Land of Rhododendron🌸#SBS Sombaria Family 🥳 9th April 2022

Кореллы Пчёлка и Лютик гуляют по полу / Paigle and Honeybee the cockatiels on a walk

Gorgeous Crystal Jewelry Unboxing, Lavender Moon Quartz, Jade and Rainbow Tourmaline! ASMR Sounds!

Unbox Samsung Galaxy Z Flip 3 + Buds 2 | Cherryl Thuy

The Delicates "Lavender Trees" (Band of Bigfoot Studio: Practice)

Улыбайтесь, вас снимает "Ланцет"

Ակնաբույժն արևելքից: Ժանինը Հայաստանում վերագտել է գործն ու բարեկամներին:

Un-List 101: Jovan
За каждым успешным каналом стоит личность, идея и сотни часов кропотливого труда. Если вы здесь, значит, автор «Горячий сон» уже сумел зацепить ваше внимание своим уникальным стилем или подачей. А мы на RUVIDEO позаботились о том, чтобы вы могли изучить весь архив его работ в максимально комфортных условиях — без лишней суеты и преград.
Почему за работами канала «Горячий сон» так интересно наблюдать? Всё просто: это честный контент, который находит отклик в сердцах зрителей. На нашем ресурсе вы можете смотреть онлайн все видео любимого автора бесплатно и в хорошем качестве. Нам важно, чтобы вы видели каждую деталь и слышали каждый нюанс, поэтому мы используем только стабильные плееры из открытых источников Rutube.
Следите за новинками канала, пересматривайте старые шедевры и открывайте для себя новые грани творчества «Горячий сон». Мы постоянно обновляем ленту, чтобы у вас под рукой всегда были самые свежие выпуски. Никаких сложных регистраций — только вы и творчество, которое вдохновляет. Приятного вам путешествия по миру авторского контента на RUVIDEO!
Видео взято из открытых источников Rutube. Если вы правообладатель, обратитесь к первоисточнику.